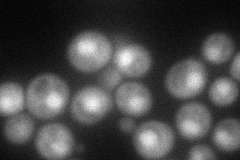
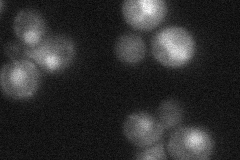
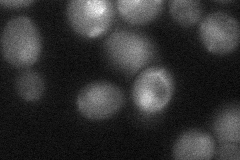
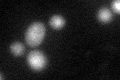

View description
Elongin C, involved in transcription elongation as a heterodimer with Ela1p; required for ubiquitin-dependent degradation of Rpo21p; plays a role in global genomic nucleotide excision repair; expression highly upregulated during sporulation
Localization:
Intensity:
Fold change:
Significance:
-
C’ GFP library in SD

nucleus:cytosol20 -
N' NOP1pr-GFP in SD

cytosol,nucleus79.585 -
N' TEF2pr-mCherry in SD
nucleus69.3075 -
N' NATIVEpr-GFP in SD
nucleus28.4418 -
N' TEF2pr-VC and Cyto-VN in SD
nucleus35.1827 -
C’ GFP library in SD+DTT
nucleus.cytosol25.241.26No -
C’ GFP library in SD+H2O2

nucleus.cytosol23.511.17No -
C’ GFP library in Starvation Media

nucleus,cytosol24.031.2No -
C’ GFP library on the background of Pup2-DaMP

nucleus:cytosol -
C’ GFP library on the background of CCT mutant

nucleus:cytosol16.48920.823968No
